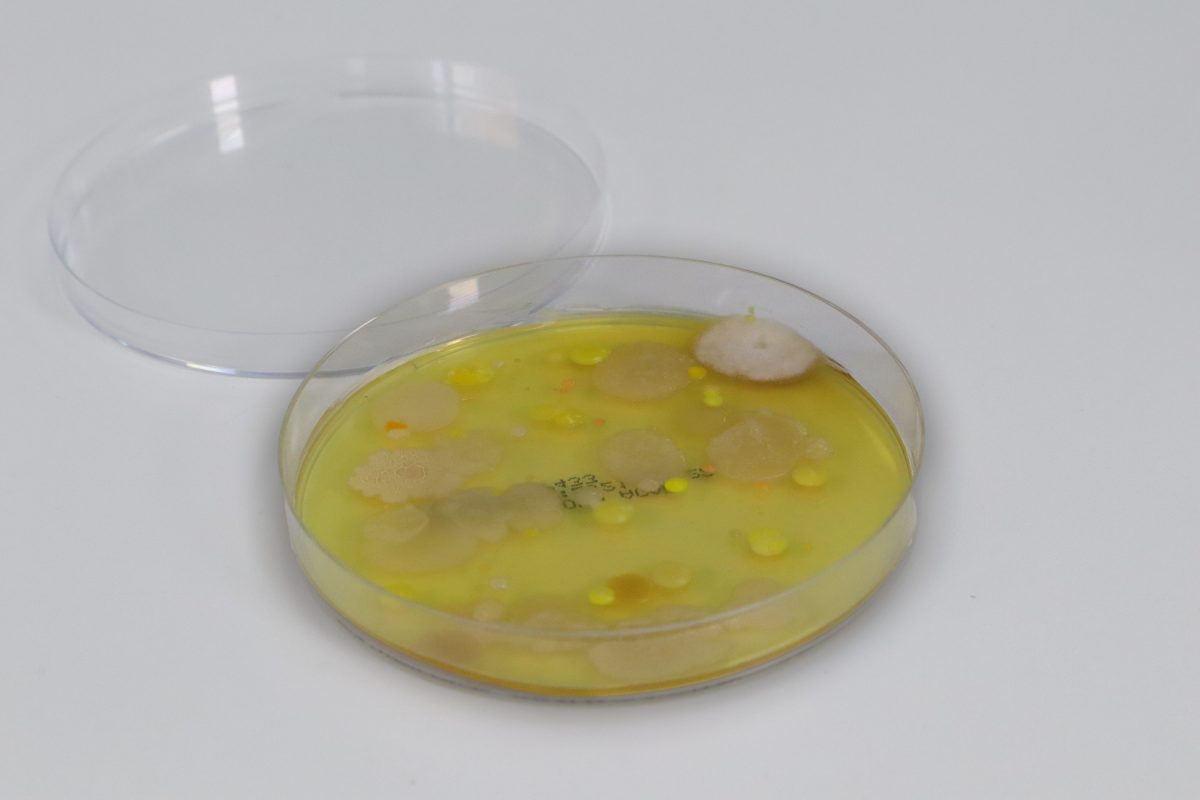
IGZ Instruments, Air sampler Spin Air

Air sampler Spin Air
Compact, portable and adjustable as required.
Main benefits
100% utilization of the agar plates
IUL’s spin technology leads to an improvement in airborne microbial collection/detection, even when sampling in medium/heavily contaminated environments (which is particularly useful for GMP Class C and D cleanrooms and regular environmental sampling).
This sampling technique utilizes 100% of the agar surface of the Petri dish for microorganisms (only 5% is used with other air samplers), avoiding the use of colony count correction tables.
Full traceability
LIMS-friendly data sets,
Printer connectivity and barcode
Scanner compatibility – all
This enables full traceability.
Easy cleaning
The lid can be sterilized,
to prevent cross-contamination
avoid.
Compliance with legal regulations
The Spin Air sampler enables compliance with USP 797 & 1116 regulations.
Simple sampling
These air samplers are compact
and portable. For an optimal
Sampling can be done on a
tripod. Should
problems with the air flow occur,
a loud acoustic alarm sounds
and the sampling is aborted.
A practical countdown function
prevents influencing the
Results by the user.
By activating the mode
“Delayed start” can be the
Contamination of the collector
be avoided.
Available for 60 mm (RODAC) and
90 mm panels.
IGZ Instruments AG - Your inquiry forAir sampler Spin Air